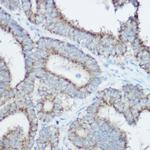
TOMM20 Antibody in Immunohistochemistry (Paraffin) (IHC (P))

Search
Invitrogen
TOMM20 Polyclonal Antibody
{{$productOrderCtrl.translations['antibody.pdp.commerceCard.promotion.promotions']}}
{{$productOrderCtrl.translations['antibody.pdp.commerceCard.promotion.viewpromo']}}
{{$productOrderCtrl.translations['antibody.pdp.commerceCard.promotion.promocode']}}: {{promo.promoCode}} {{promo.promoTitle}} {{promo.promoDescription}}. {{$productOrderCtrl.translations['antibody.pdp.commerceCard.promotion.learnmore']}}

Please note: We are reviewing Western blot images included in the antibody testing data in our catalog, including those provided by third parties. Unless expressly labeled or annotated as “raw-unedited”, Western blot images included in the antibody testing data in our catalog may have been edited, optimized or otherwise adjusted for presentation.
产品信息
PA5-120501
种属反应
宿主/亚型
分类
类型
抗原
偶联物
形式
浓度
规格
纯化类型
保存液
内含物
保存条件
运输条件
RRID
产品详细信息
Positive test controls include: 293T, THP-1, MCF7, mouse liver, mouse kidney, mouse brain, rat thymus. The target is usually found in the following locations: Mitochondrion outer membrane, Single-pass membrane protein.
Immunogen sequence: YCIYFDRKRR SDPNFKNRLR ERRKKQKLAK ERAGLSKLPD LKDAEAVQKF FLEEIQLGEE LLAQGEYEKG VDHLTNAIAV CGQPQQLLQV LQQTLPPPVF QMLLTKLPTI SQRIVSAQSL AEDDVE
靶标信息
The mitochondrial preprotein translocases of the outer membrane (Tom) is a multisubunit protein complex that facilitates the import of nucleus-encoded precursor proteins across the mitochondrial outer membrane. The Tom machinery consists of import receptors for the initial binding of cytosolically synthesized preproteins and a general import pore (GIP) for the membrane translocation of various preproteins into the mitochondria. The import receptors include Tom20 and Tom22, which form a heteromeric receptor complex that initiates the insertion of newly synthesized proteins into the outer membrane and then directs the precursor protein into the GIP. In yeast, Tom22 is the essential component of the import receptor complex as it functions as both a receptor for the preproteins and serves as a docking point for both Tom20 and the GIP.
仅用于科研。不用于诊断过程。未经明确授权不得转售。
篇参考文献 (0)
生物信息学
蛋白别名: Mitochondrial 20 kDa outer membrane protein; Mitochondrial import receptor subunit TOM20 homolog; outer mitochondrial membrane receptor rTOM20; Outer mitochondrial membrane receptor Tom20
基因别名: 1810060K07Rik; BB284719; Gm19268; KIAA0016; MAS20; mKIAA0016; MOM19; TOM20; TOMM20
UniProt ID: (Rat) Q62760, (Mouse) Q9DCC8
Entrez Gene ID: (Rat) 266601, (Mouse) 67952




